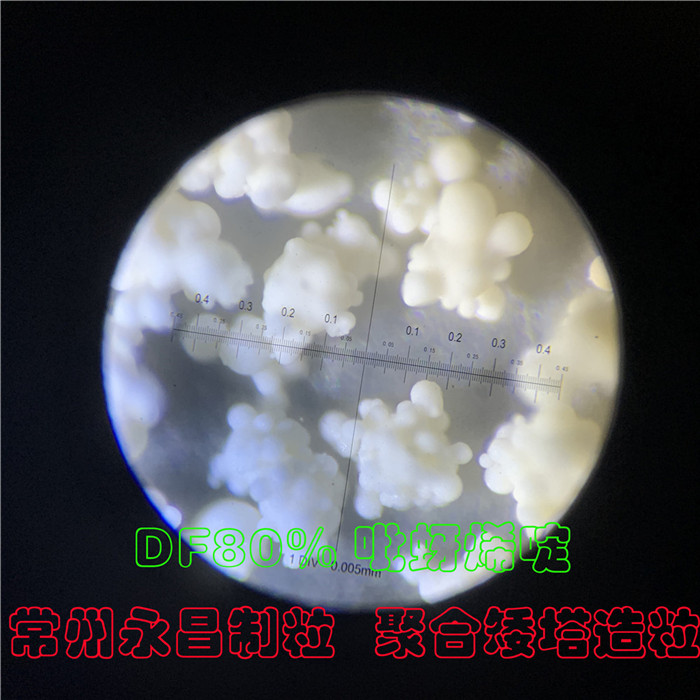
246天天免费资料网

江苏省常州市金坛区儒林镇园区西路98号7幢
邮编:213116
联系人:成经理
手机:13806126909
电话:0519-88911909 88912909
传真:0519-88913909
邮箱:[email protected]
网址:
近期DF干悬浮剂矮塔造粒试验取得成功,解决DF高塔润湿度不好问题
近期试的DF干悬浮剂:50%噻虫嗪.烯啶虫胺、50%氟啶虫酰胺.啶虫脒、80%吡蚜酮+呋虫胺、80%吡蚜烯啶、12%噻霉酮、60%吡唑代森联、50%戍唑醇+25%肟菌酯、40%呋虫胺+20%烯啶虫胺、75%百菌清、20%烯啶虫胺+10%氟啶虫酰胺。采用我公司新研发的喷雾流化造粒塔试验,DF颗粒的崩解、润湿度、耐磨性等都比现在市场上的高塔好。
目前我公司有小试和中试喷雾流化造粒塔,小试设备5-10kg浆料做试验,中试设备50-100kg浆料试验,欢迎有需要的农药企业朋友带料试机。
主要用于溶液、悬浮液或乳浊液等直接干燥成葡萄状多孔颗粒,流动性好,速溶性好,常规的喷雾塔干燥后,是细粉(需二次造粒)或单颗球形颗粒(高塔低温时大的单颗粒不易干燥粘壁、速溶性差)。
专利号:CN202122318972.3